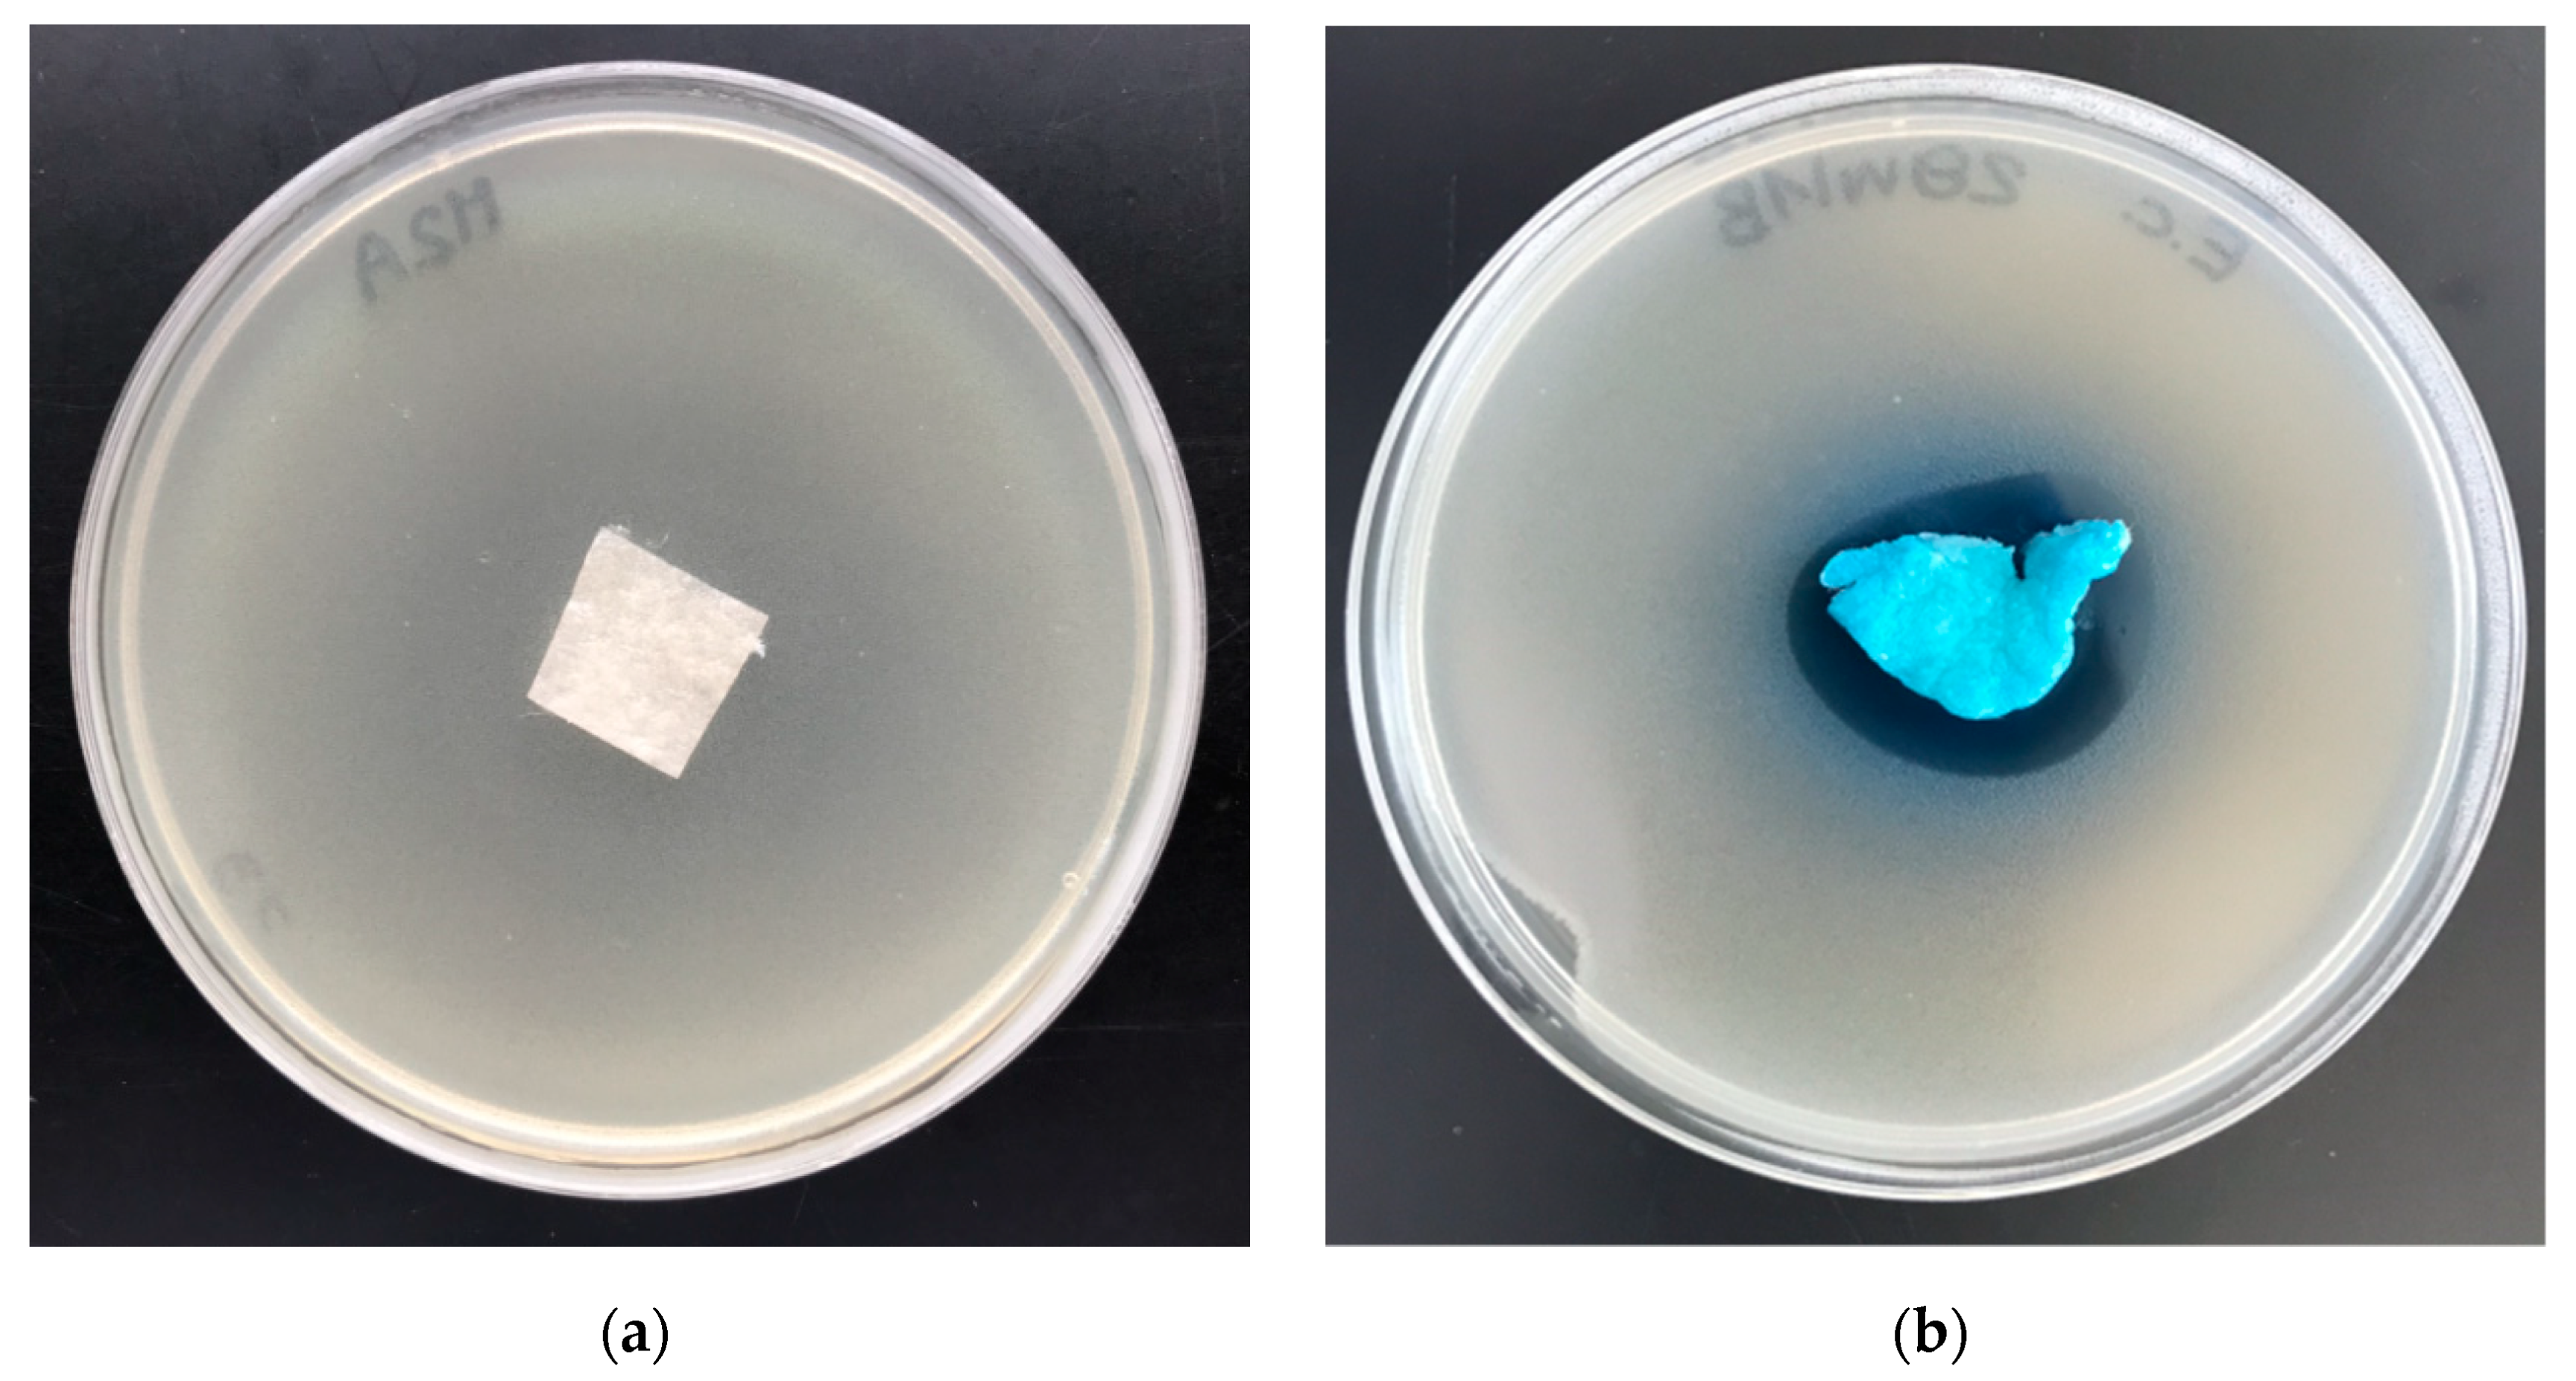
Marinedrugs 18 00660 g010
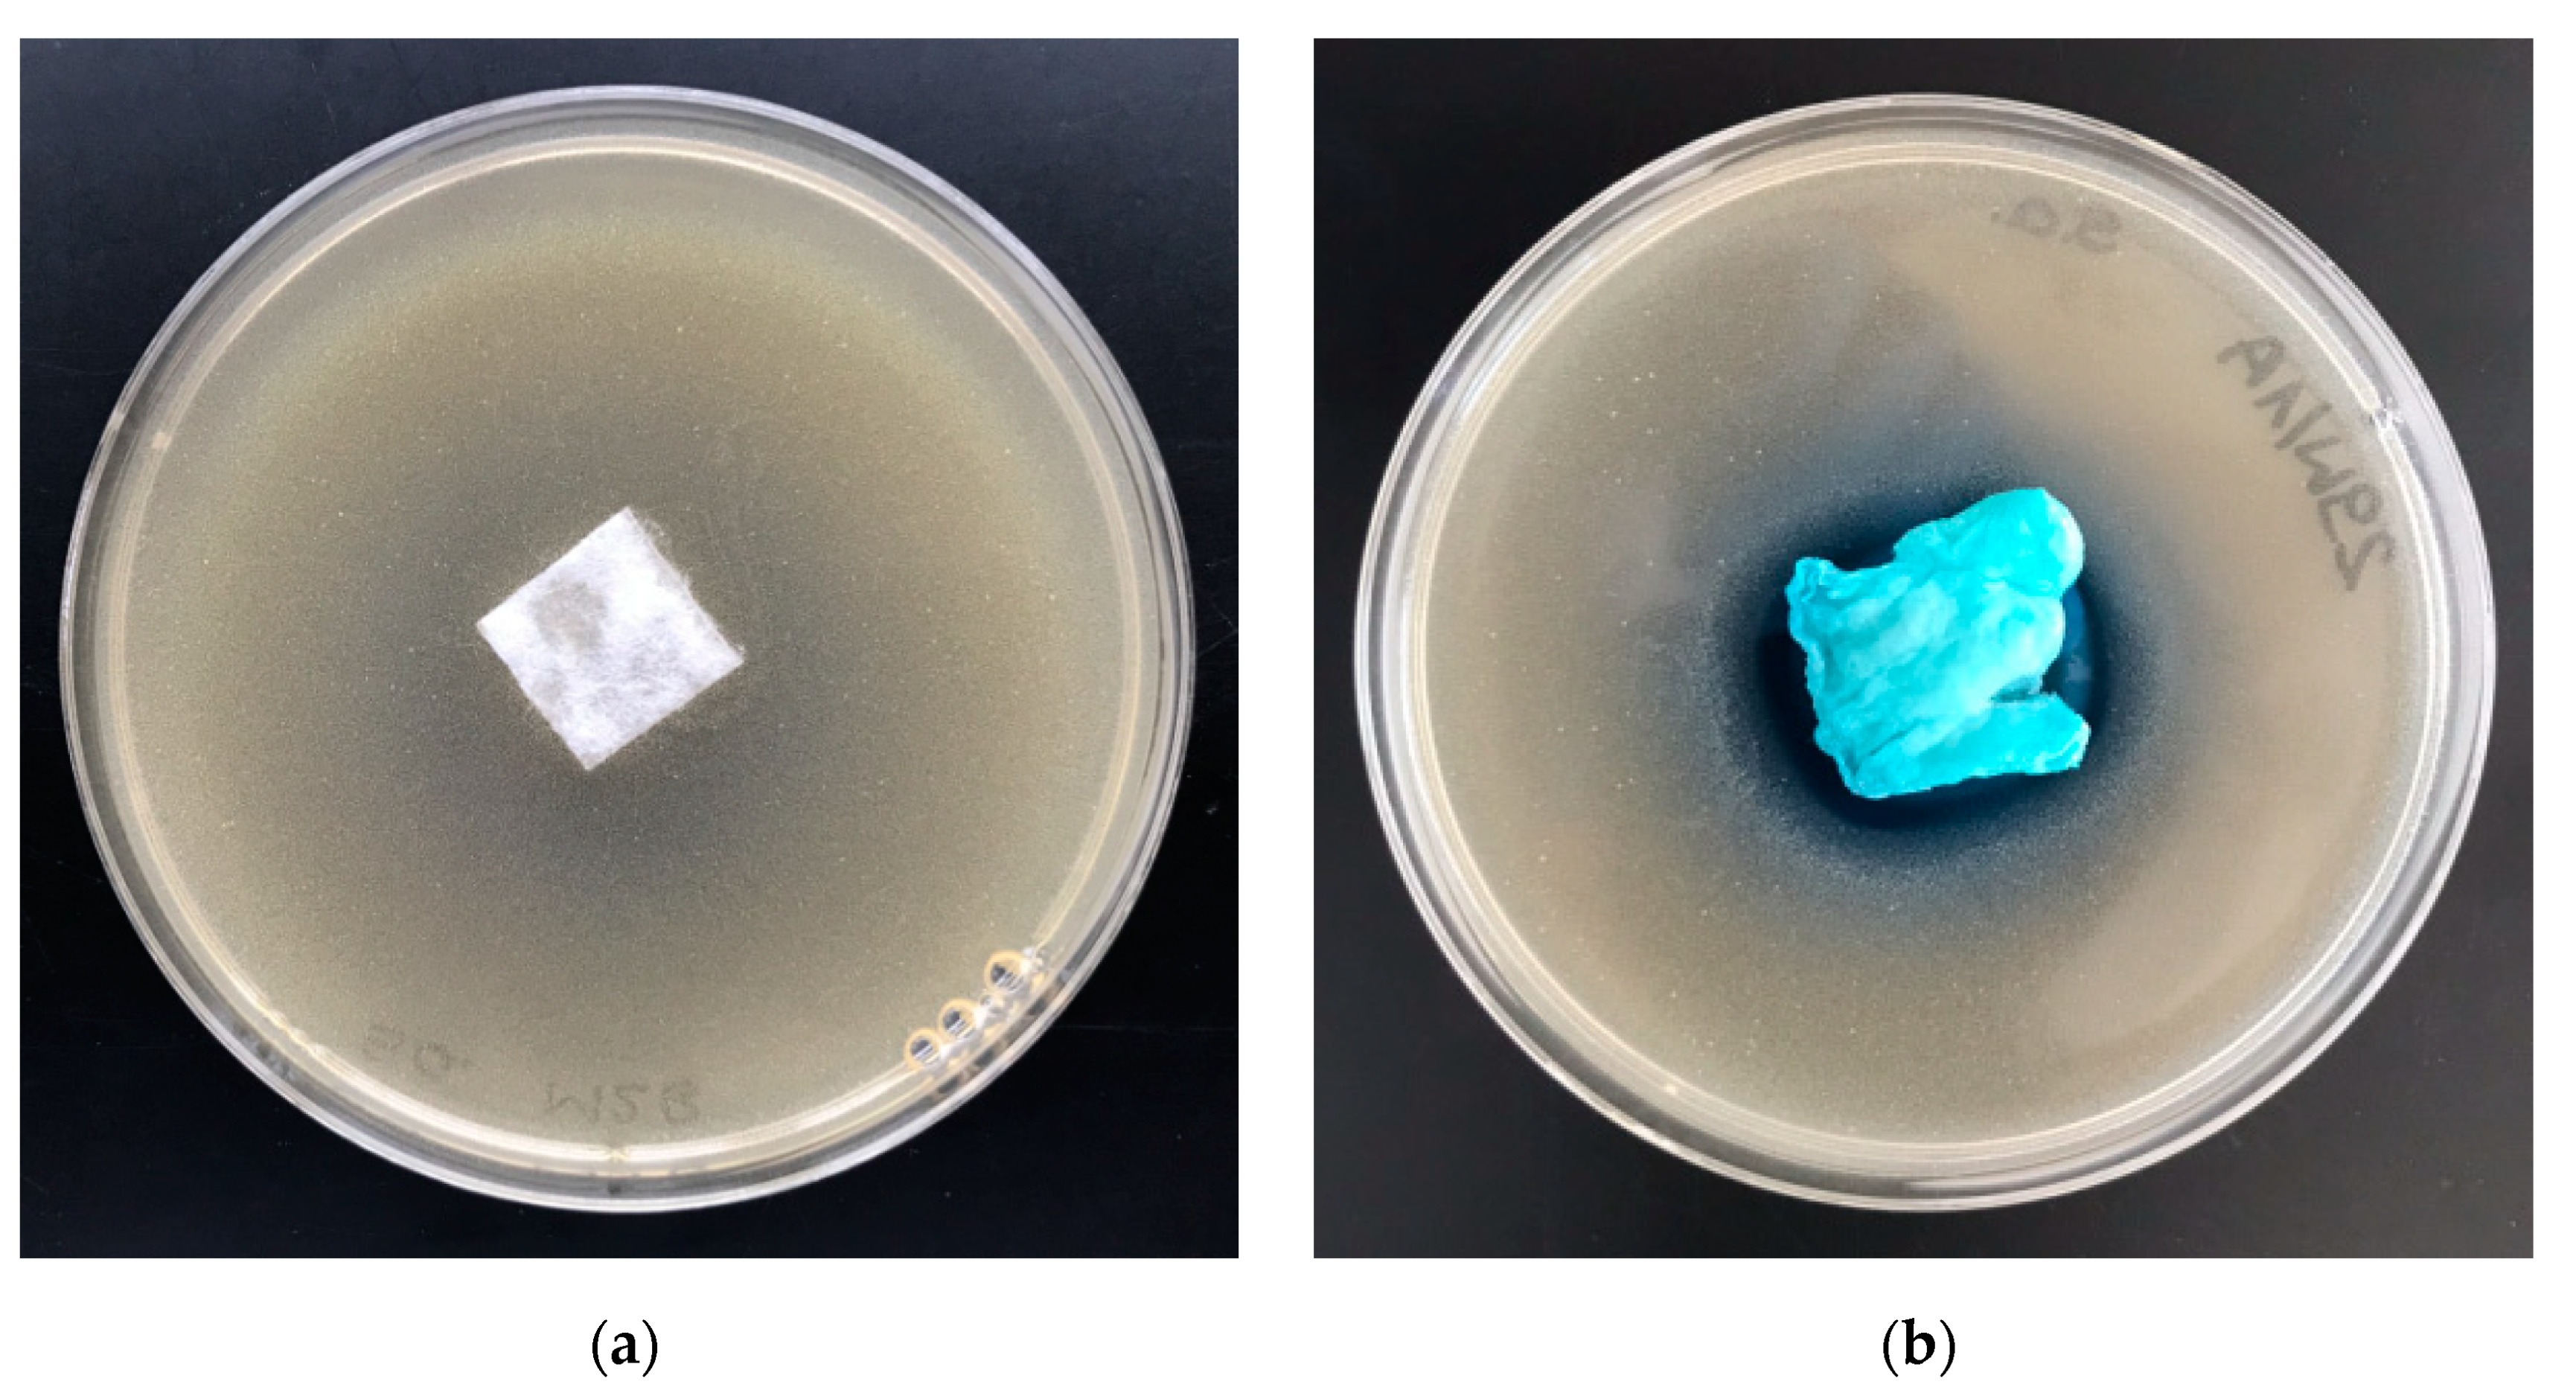
Marinedrugs 18 00660 g011
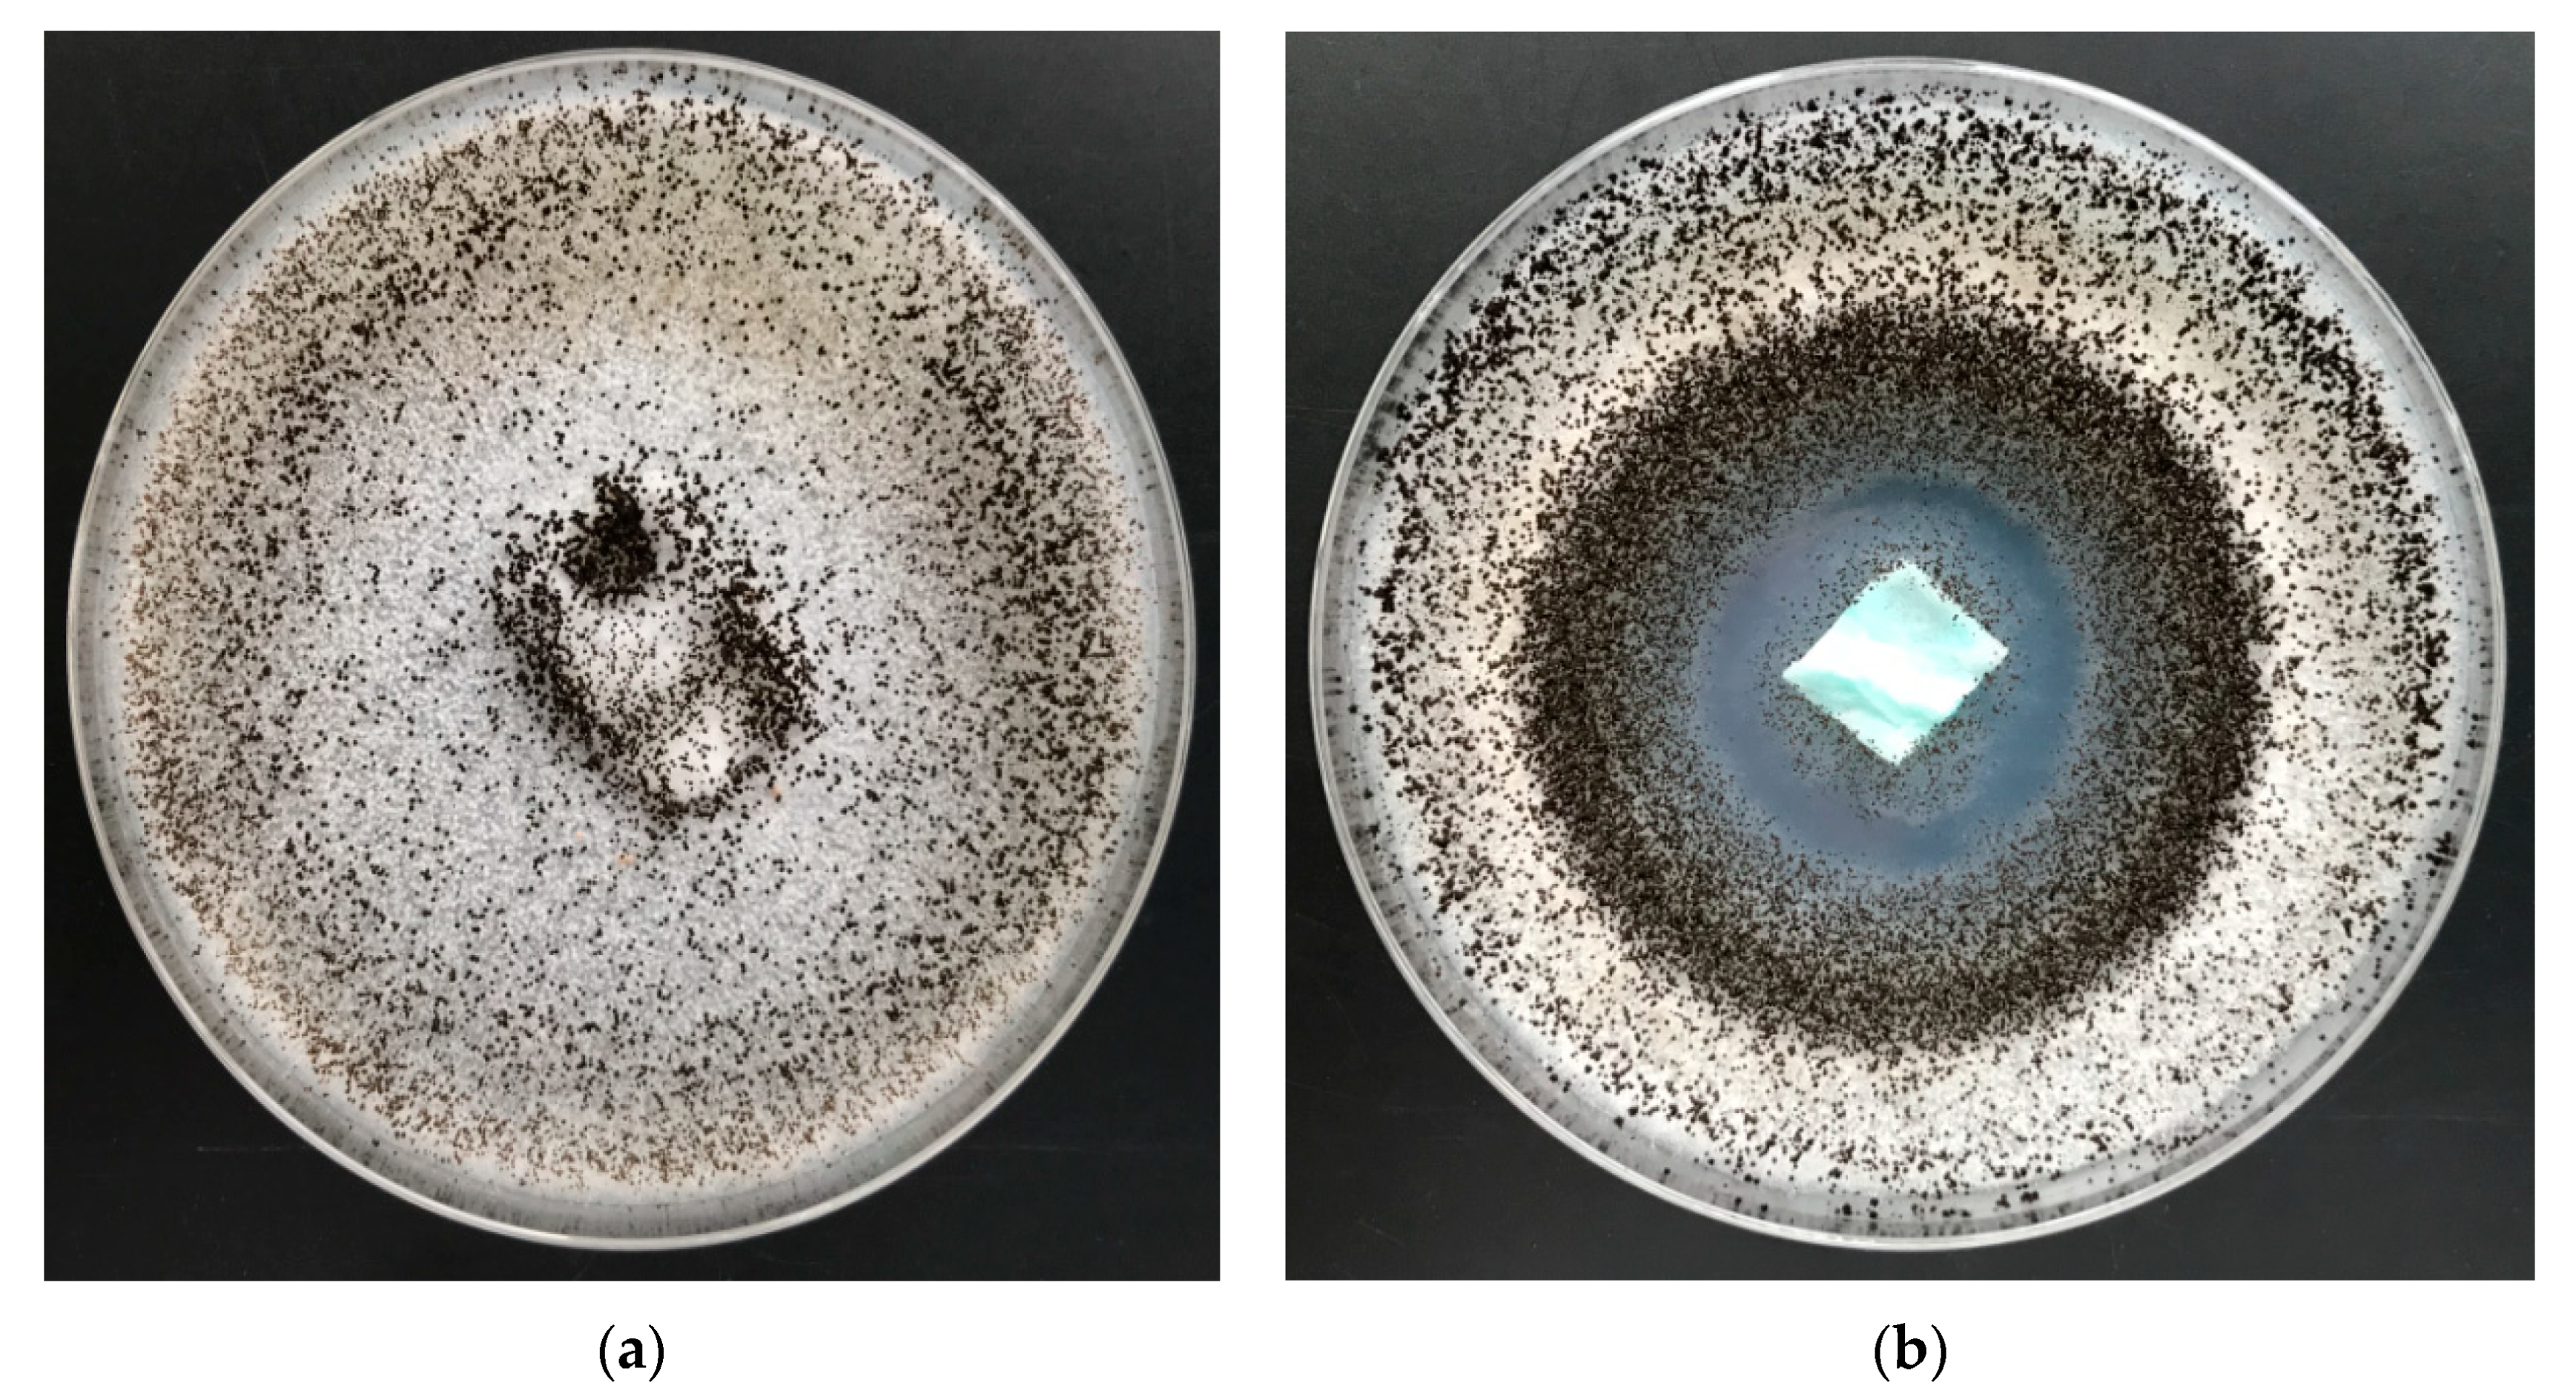
Marinedrugs 18 00660 g012
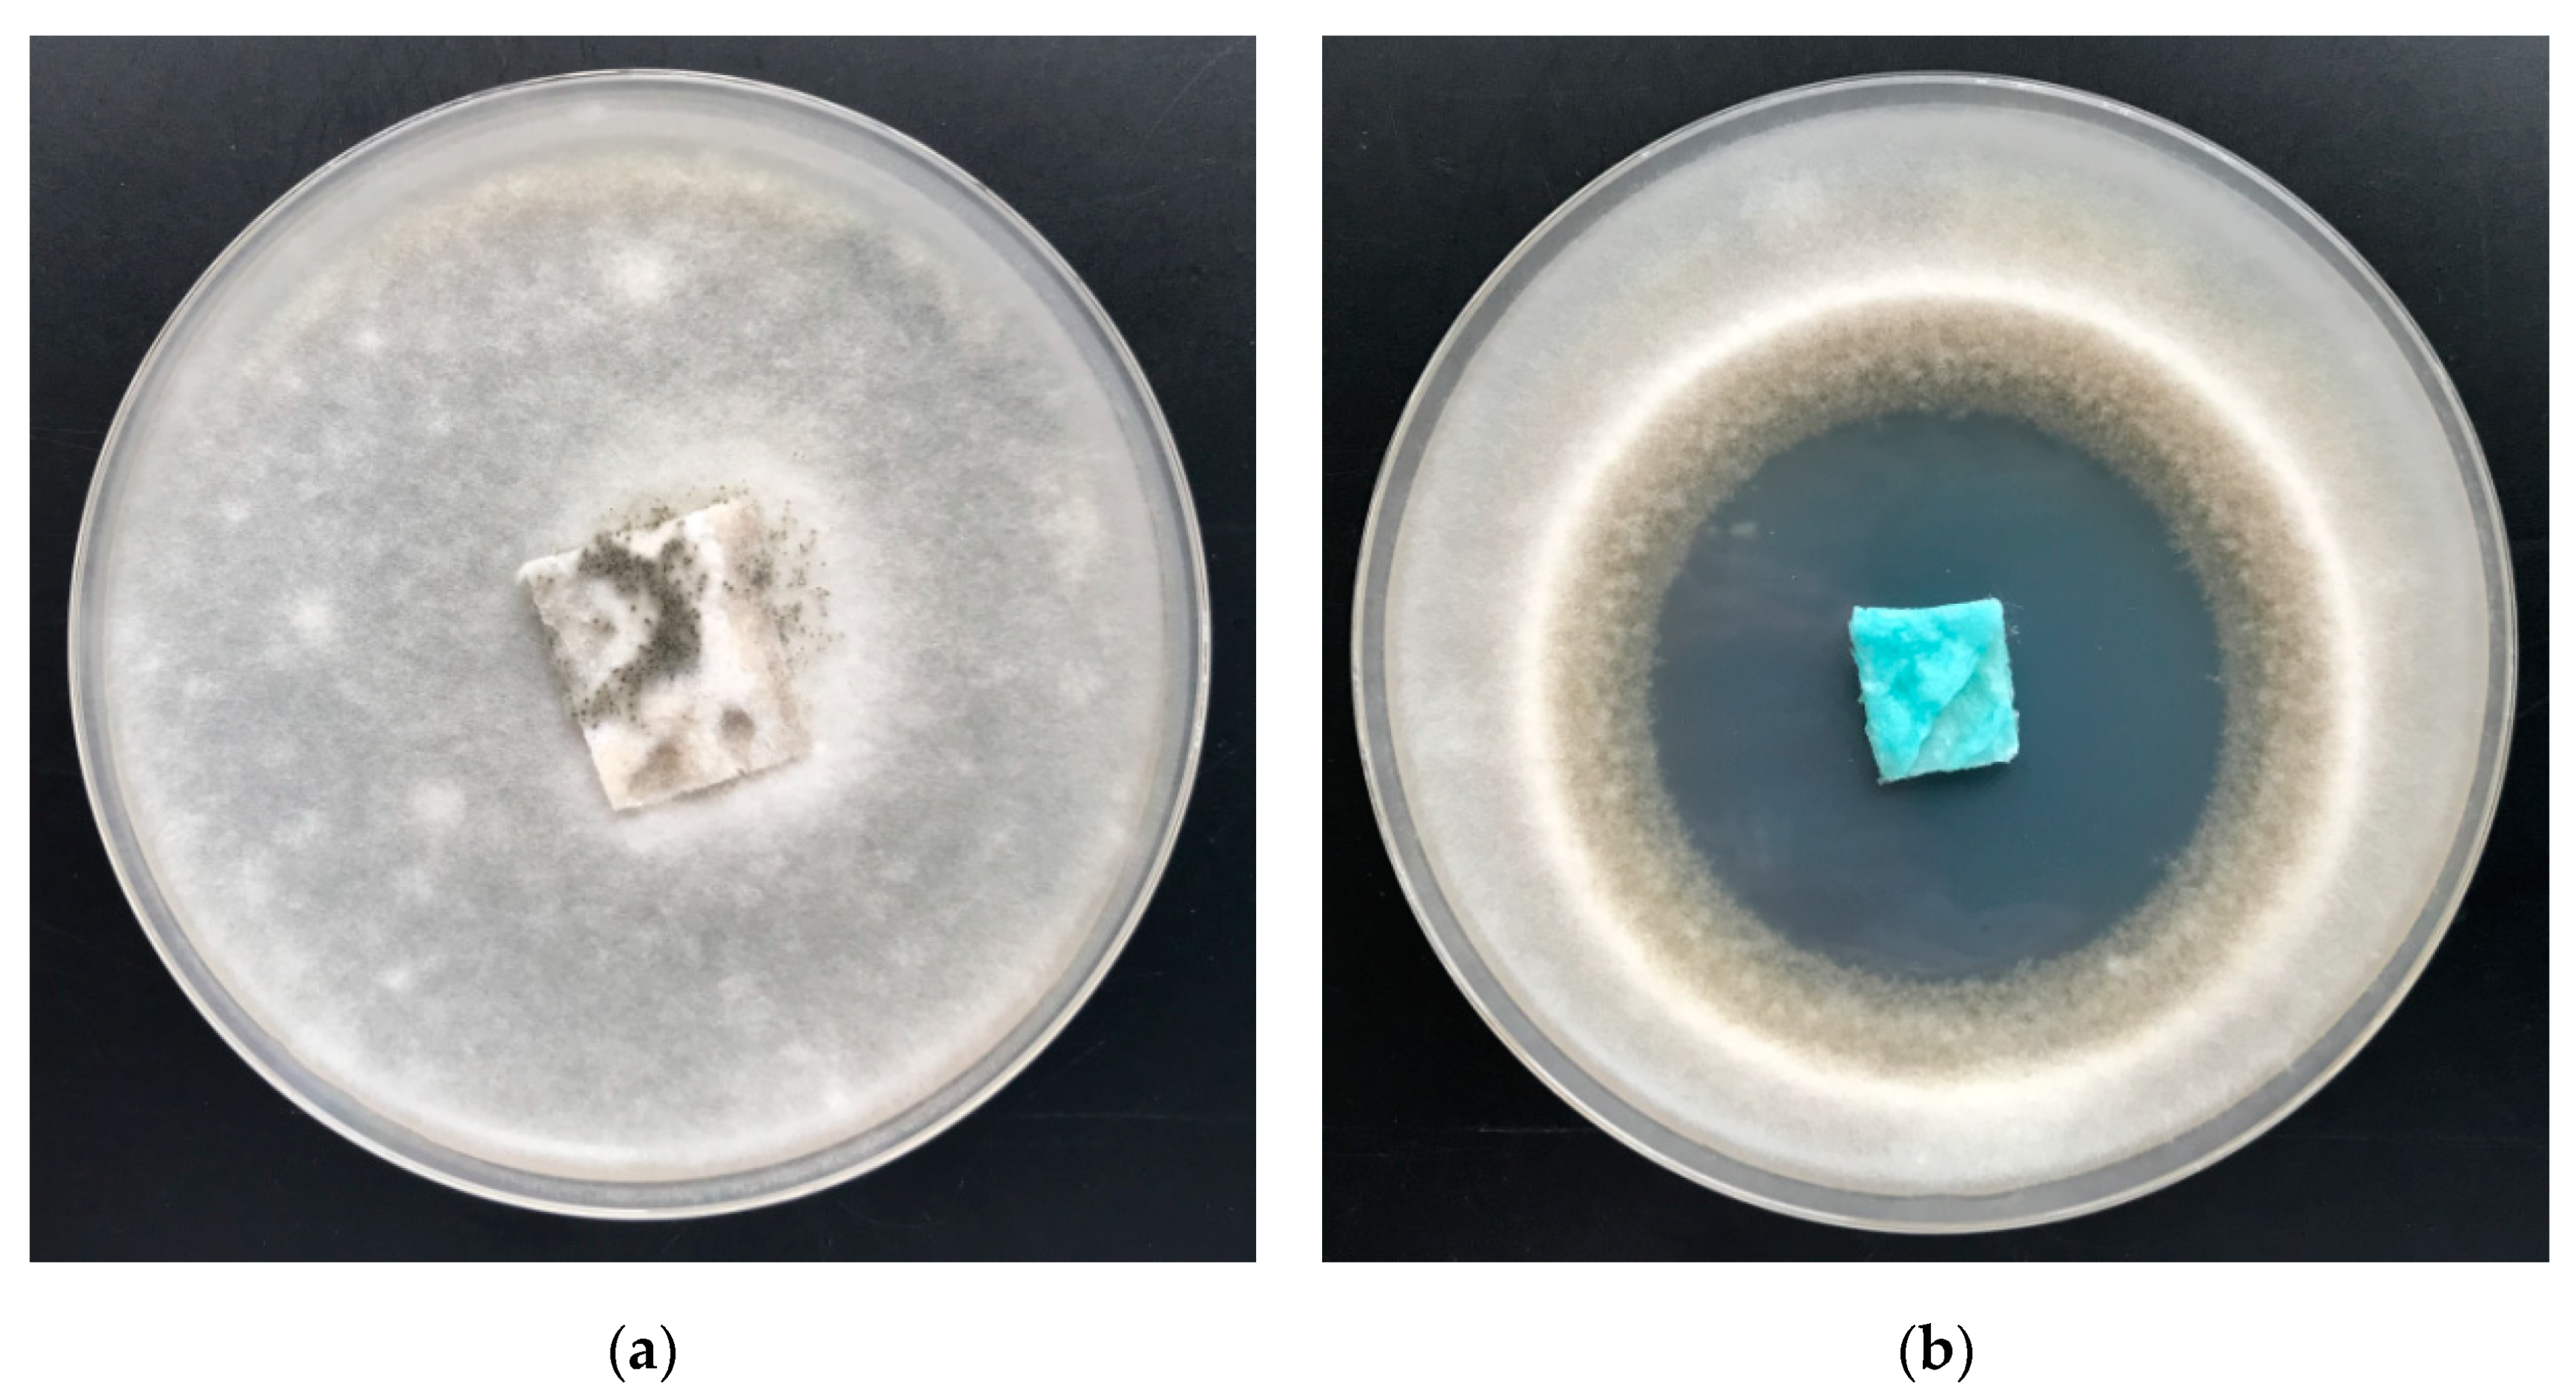
Marinedrugs 18 00660 g013

Physical Properties, Chemical Analysis, and Evaluation of Antimicrobial Response of New Polylactide/Alginate/Copper Composite Materials
Abstract
1. Introduction
2. Results and Discussion
2.1. Preparation of PLA–ALG–Cu2+ Composites
2.2. Scanning Electron Microscopy
2.3. FAAS
2.4. ATR–FTIR Spectra
2.5. Specific Surface Area, Total Pore Volume, and Average Pore Diameter Measurement
2.6. UV-VIS Analysis and Determination of the Protective Properties against UV Radiation
3. Antimicrobial Properties
3.1. Antibacterial Activity
3.2. Antifungal Activity
4. Conclusions
5. Materials and Methods
5.1. Materials
- Poly(lactic acid) (PLA) type Ingeo™ Biopolymer 3251D, in the form of granulates was purchased from NatureWorks LLC (Minnetonka, MN, USA), Tmp = 160–170 °C, MFR = 30–40 g/10min (190 °C/2.16 kg) and was used for the forming of samples of nonwoven fabrics;
- Alginic acid sodium salt (CAS Number 9005-38-3, the molecular weight: 120,000–190,000 g/moL, mannuronic acid to guluronic acid–M/G ratio: 1.56) from Millipore Sigma (St. Louis, MO, USA), was used for surface modification of polymer nonwovens;
- Copper(II) chloride, CuCl2, 97% (CAS Number: 7447-39-4) from Millipore Sigma (St. Louis, MO, USA) was used for surface modification of nonwoven composite;
- Bacterial strains: Escherichia coli (ATCC 25922) and Staphylococcus aureus (ATCC 6538) were purchased from Microbiologics (St. Cloud, MN, USA).
- Fungal strains: Aspergillus niger van Tieghem (ATCC 6275) and Chaetomium globosum (ATCC 6205) were purchased from Microbiologics (St. Cloud, MN, USA).
5.2. Methods
5.2.1. Nonwoven Fabrics
5.2.2. Dip–Coating Modification
5.2.3. Scanning Electron Microscopy/Energy–Dispersive X–ray Spectroscopy (SEM/EDS)
5.2.4. Flame Atomic Absorption Spectrometry (FAAS)
5.2.5. Attenuated Total Reflection Fourier–Transform Infrared Spectroscopy (ATR–FTIR)
5.2.6. Specific Surface Area, Total Pore Volume, and Average Pore Diameter Measurement
5.2.7. UV-VIS Analysis and Determination of the Protective Properties against UV Radiation
5.2.8. Antibacterial Activity
5.2.9. Antifungal Activity
Author Contributions
Funding
Acknowledgments
Conflicts of Interest
References
- Garlotta, D. A literature review of poly (lactic acid). J. Polym. Environ. 2001, 9, 63–84. [Google Scholar] [CrossRef]
- Auras, R.; Lim, L.T.; Selke, S.E.M.; Tsuji, H. Poly (Lactic Acid): Synthesis, Structures, Properties, Processing, and Applications; John Wiley & Sons, Inc.: Hoboken, NJ, USA, 2010. [Google Scholar] [CrossRef]
- Bordes, P.; Pollet, E.; Avérous, L. Nano–biocomposites: Biodegradable polyester/nanoclay systems. Prog. Polym. Sci. 2009, 34, 125–155. [Google Scholar] [CrossRef]
- Park, S.B.; Lih, E.; Park, K.S.; Joung, Y.K.; Han, D.K. Biopolymer–based functional composites for medical applications. Prog. Polym. Sci. 2017, 68, 77–105. [Google Scholar] [CrossRef]
- Koh, J.J.; Zhang, X.; He, C. Fully biodegradable Poly(lactic acid)/Starch blends: A review of toughening strategies. Int. J. Biol. Macromol. 2018, 109, 99–113. [Google Scholar] [CrossRef]
- Granados–Hernández, M.V.; Serrano–Bello, J.; Montesinos, J.J.; Alvarez–Gayosso, C.; Medina–Velázquez, L.A.; Alvarez–Fregoso, O.; Alvarez–Perez, M.A. In vitro and in vivo biological characterization of poly (lactic acid) fiber scaffolds synthesized by air jet spinning. J. Biomed. Mater. Res. B Appl. Biomater. 2018, 106, 2435–2446. [Google Scholar] [CrossRef]
- Alex, A.; Ilango, K.N.; Ghosh, P. Comparative role of chain scission and solvation in the biodegradation of polylactic acid (PLA). J. Phys. Chem. B 2018, 122, 9516–9526. [Google Scholar] [CrossRef]
- Nofar, M.; Sacligil, D.; Carreau, P.J.; Kamal, M.R.; Heuzey, M.-C. Poly (lactic acid) blends: Processing, properties and applications. Int. J. Biol. Macromol. 2019, 125, 307–360. [Google Scholar] [CrossRef]
- Rogovina, S.Z.; Aleksanyan, K.V.; Vladimirov, L.V.; Berlin, A.A. Biodegradable polymer materials based on polylactide. Russ. J. Phys. Chem. B 2019, 13, 812–818. [Google Scholar] [CrossRef]
- Kliem, S.; Kreutzbruck, M.; Bonten, C. Review on the biological degradation of polymers in various environments. Materials 2020, 13, 4586. [Google Scholar] [CrossRef]
- Olewnik–Kruszkowska, E.; Burkowska–But, A.; Tarach, I.; Walczak, M.; Jakubowska, E. Biodegradation of polylactide–based composites with an addition of a compatibilizing agent in different environments. Int. Biodeterior. Biodegrad. 2020, 147, 104840. [Google Scholar] [CrossRef]
- Lasprilla, A.J.R.; Martinez, G.A.R.; Lunelli, B.H.; Jardini, A.L.; Filho, R.M. Poly–lactic acid synthesis for application in biomedical devices—A review. Biotechnol. Adv. 2012, 30, 321–328. [Google Scholar] [CrossRef] [PubMed]
- Zhou, J.; Han, S.; Dou, Y.; Lu, J.; Wang, C.; He, H.; Li, X.; Zhang, J. Nanostructured poly(l–lactide) matrix as novel platform for drug delivery. Int. J. Pharm. 2013, 448, 175–188. [Google Scholar] [CrossRef] [PubMed]
- Pandey, A.K.; Dwivedi, A.K. Recent advancement in wound healing dressing material. Int. J. Pharm. Sci. Res. 2019, 10, 2572–2577. [Google Scholar] [CrossRef]
- Sharif, A.; Mondal, S.; Hoque, M.E. Polylactic acid (PLA)–based nanocomposites: Processing and properties. In Bio–based Polymers and Nanocomposites: Preparation, Processing, Properties & Performance; Springer Nature Switzerland AG: Berlin/Heidelberg, Germany, 2019; pp. 233–254. [Google Scholar]
- Alam, F.; Shukla, V.R.; Varadarajan, K.M.; Kumar, S. Microarchitected 3D printed polylactic acid (PLA) nanocomposite scaffolds for biomedical applications. J. Mech. Behav. Biomed. Mater. 2020, 103, 103576. [Google Scholar] [CrossRef]
- Essa, D.; Kondiah, P.P.D.; Choonara, Y.E.; Pillay, V. The Design of poly(lactide–co–glycolide) nanocarriers for medical applications. Front. Bioeng. Biotechnol. 2020, 8, 48. [Google Scholar] [CrossRef]
- Wu, D.; Spanou, A.; Diez–Escudero, A.; Persson, C. 3D–printed PLA/HA composite structures as synthetic trabecular bone: A feasibility study using fused deposition modeling. J. Mech. Behav. Biomed. Mater 2020, 103, 103608. [Google Scholar] [CrossRef]
- Barceloux, D.G.; Barceloux, D. Copper. J. Toxicol. Clin. Toxicol. 1999, 37, 217–230. [Google Scholar] [CrossRef]
- Gaetke, L.M.; Chow–Johnson, H.S.; Chow, C.K. Copper: Toxicological relevance and mechanisms. Arch. Toxicol. 2014, 88, 1929–1938. [Google Scholar] [CrossRef]
- Scopus Base. 5476 Documents Results on Antibacterial Copper. Available online: https://www-1scopus-1com-10000147v00b7.han.p.lodz.pl/results/results.uri?numberOfFields=0&src=s&clickedLink=&edit=&editSaveSearch=&origin=searchbasic&authorTab=&affiliationTab=&advancedTab=&scint=1&menu=search&tablin=&searchterm1=antibacterial+metallic+copper&field1=TITLE_ABS_KEY&dateType=Publication_Date_Type&yearFrom=Before+1960&yearTo=Present&loadDate=7&documenttype=All&accessTypes=All&resetFormLink=&st1=antibacterial+metallic+copper&st2=&sot=b&sdt=b&sl=44&s=TITLE–ABS–KEY%28antibacterial+metallic+copper%29&sid=f8209a25a17607eae8dff3520803ccdf&searchId=f8209a25a17607eae8dff3520803ccdf&txGid=19f07020ab9ba0c00ce0a023d21c5278&sort=plf–f&originationType=b&rr= (accessed on 12 December 2020).
- Saidin, S.; Jumat, M.A.; Mohd Amin, N.A.A.; Saleh Al–Hammadi, A.S. Organic and inorganic antibacterial approaches in combating bacterial infection for biomedical application. Mater. Sci. Eng. C 2021, 118, 111382. [Google Scholar] [CrossRef]
- Sthoer, A.; Hladılkova, J.; Lund, M.; Tyrode, E. Molecular insight into carboxylic acid–alkali metal cations interactions: Reversed affinities and ion–pair formation revealed by non–linear optics and simulations. Phys. Chem. Chem. Phys. 2019, 21, 11329–11344. [Google Scholar] [CrossRef]
- Draget, K.L.; Taylor, C. Chemical, physical and biological properties of alginates and their biomedical implications. Food Hydrocoll. 2011, 25, 251–256. [Google Scholar] [CrossRef]
- Polyzois, G.L.; Andreopoulos, A.G. Stability of some soluble alginate solutions. Biomaterials 1985, 6, 68–69. [Google Scholar] [CrossRef]
- Achmon, Y.; Dowdy, F.R.; Simmons, C.W.; Zohar–Perez, C.; Rabinovitz, Z.; Nussinovitch, A. Degradation and bioavailability of dried alginate hydrocolloid capsules in simulated soil system. J. Appl. Polym. Sci. 2019, 136, 48142. [Google Scholar] [CrossRef]
- Zhang, C.; Show, P.L.; Ho, S.H. Progress and perspective on algal plastics—A critical review. Bioresour. Technol. 2019, 289, 121700. [Google Scholar] [CrossRef] [PubMed]
- Zhang, W.; Xia, X.; Zhang, Z. Alginate lyase of a novel algae fermentation strain. Chem. Biochem. Eng. Q. 2019, 33, 125–131. [Google Scholar] [CrossRef]
- Sun, H.; Gao, L.; Xue, C.; Mao, X. Marine–polysaccharide degrading enzymes: Status and prospects. Compr. Rev. Food Sci. Food Saf. 2020, 19, 2767–2796. [Google Scholar] [CrossRef]
- Lee, K.Y.; Mooney, D.J. Alginate: Properties and biomedical applications. Prog. Polym. Sci. 2012, 37, 106–126. [Google Scholar] [CrossRef]
- Pawar, S.N.; Edgar, K.J. Alginate derivatization: A review of chemistry, properties and applications. Biomaterials 2012, 33, 3279–3305. [Google Scholar] [CrossRef]
- Venkatesan, J.; Bhatnagar, I.; Manivasagan, P.; Kang, K.H.; Kims, K.A. Alginate composites for bone tissue engineering: A review. Int. J. Biol. Macromol. 2015, 72, 269–281. [Google Scholar] [CrossRef]
- Fernando, I.P.S.; Kim, D.; Nah, J.W.; Jeon, Y.J. Advances in functionalizing fucoidans and alginates (bio)polymers by structural modifications: A review. Chem. Eng. J. 2019, 355, 33–48. [Google Scholar] [CrossRef]
- Kuznetsova, T.A.; Andryukov, B.G.; Besednova, N.N.; Zaporozhets, T.S.; Kalinin, A.V. Marine algae polysaccharides as basis for wound dressings, drug delivery, and tissue engineering: A review. J. Mar. Sci. Eng. 2020, 8, 481. [Google Scholar] [CrossRef]
- Yokoyama, F.; Achife, C.E.; Takahira, K.; Yamashita, Y.; Monobe, K.; Kusano, F.; Nishi, K. Morphologies of oriented alginate gels crosslinked with various divalent metal ions. J. Macromol. Sci., Part B 1992, 31, 463–483. [Google Scholar] [CrossRef]
- García–Torres, J.; Gispert, C.; Gómez, E.; Vallés, E. Alginate electrodeposition onto three–dimensional porous Co–Ni films as drug delivery platforms. Phys. Chem. Chem. Phys. 2015, 17, 1630–1636. [Google Scholar] [CrossRef] [PubMed]
- Pistone, S.; Qoragllu, D.; Smistad, G.; Hiorth, M. Formulation and preparation of stable cross–linked alginate–zinc nanoparticles in the presence of a monovalent salt. Soft Matter 2015, 11, 5765–5774. [Google Scholar] [CrossRef]
- Pérez–Madrigal, M.M.; Torras, J.; Casanovas, J.; Haring, M.; Alemán, C.; Díaz, D.D. Paradigm shift for preparing versatile M2+–free gels from unmodified sodium alginate. Biomacromolecules 2017, 18, 2967–2979. [Google Scholar] [CrossRef]
- Frígols, B.; Martí, M.; Salesa, B.; Hernández–Oliver, C.; Aarstad, O.; Teialeret Ulset, A.S.; Sӕtrom, G.I.; Aachmann, F.L.; Serrano–Aroca, A. Graphene oxide in zinc alginate films: Antibacterial activity, cytotoxicity, zinc release, water sorption/diffusion, wettability and opacity. PLoS ONE 2019, 14, e0212819. [Google Scholar] [CrossRef]
- Munhoz, D.R.; Bernardo, M.P.; Malafattia, J.M.; Moreira, F.K.V.; Mattoso, L.H.C. Alginate films functionalized with silver sulfadiazine–loaded [Mg–Al] layered double hydroxide as antimicrobial wound dressing. Int. J. Biol. Macromol. 2019, 141, 504–510. [Google Scholar] [CrossRef]
- Salesa, B.; Martí, M.; Frígols, O.B.; Serrano–Aroca, A. Carbon nanofibers in pure form and in calcium alginate composites films: New cost–effective antibacterial biomaterials against the life–threatening multidrug–resistant Staphylococcus epidermidis. Polymers 2019, 11, 453. [Google Scholar] [CrossRef]
- Zahran, M.; Marei, A.H. Innovative natural polymer metal nanocomposites and their antimicrobial activity. Int. J. Biol. Macromol. 2019, 136, 586–596. [Google Scholar] [CrossRef]
- Susilowati, E.; Masykuri, M.; Hastuti, B. Preparation of nanocomposite silver–chitosan–alginate film as antibacterial material. J. Phys. Conf. Ser. 2020, 1503, 012029. [Google Scholar] [CrossRef]
- Porter, G.C.; Schwass, D.R.; Tompkins, G.R.; Bobbala, S.K.R.; Medlicott, N.J.; Meledandri, C.J. AgNP/Alginate Nanocomposite hydrogel for antimicrobial and antibiofilm applications. Carbohyd. Polym. 2021, 251, 117017. [Google Scholar] [CrossRef] [PubMed]
- Cataldo, S.; Gianguzza, A.; Pettignano, A.; Villaescusa, I. Mercury(II) removal from aqueous solution by sorption onto alginate, pectate and polygalacturonate calcium gel beads. A kinetic and speciation based equilibrium study. React. Funct. Polym. 2013, 73, 207–217. [Google Scholar] [CrossRef]
- Shang, Y.; Yu, X. Screening of algae material as a filter for heavy metals in drinking water. Algal Res. 2015, 12, 258–261. [Google Scholar] [CrossRef]
- Fuks, L.; Herdzik–Koniecko, I.; Polkowska–Motrenko, H.; Oszczak, A. Novel procedure for removal of the radioactive metals from aqueous wastes by the magnetic calcium alginate. Int. J. Environ. Sci. Technol. 2018, 15, 2657–2668. [Google Scholar] [CrossRef]
- Ali, A.M.; Husson, J.; Monney, S.; Franchi, M.; Knorr, M.; Euvrard, M. Biosorption of Pb(II) ions from aqueous solution using alginates extracted from Djiboutian seaweeds and deposited on silica particles. Pure Appl. Chem. 2019, 91, 459–475. [Google Scholar] [CrossRef]
- Biswas, S.; Meikap, B.C.; Sen, T.K. Adsorptive removal of aqueous phase copper (Cu2+) and nickel (Ni2+) metal ions by synthesized biochar–biopolymeric hybrid adsorbents and process optimization by Response Surface Methodology (RSM). Water Air Soil Pollut. 2019, 230, 197. [Google Scholar] [CrossRef]
- Borgiallo, A.; Rojas, R. Reactivity and heavy metal removal capacity of calcium alginate beads loaded with Ca–Al layered double hydroxides. Chem. Eng. 2019, 3, 22. [Google Scholar] [CrossRef]
- Li, J.; He, J.; Huang, Y. Role of alginate in antibacterial finishing of textiles. Int. J. Biol. Macromol. 2017, 94, 466–473. [Google Scholar] [CrossRef]
- Grace, M.; Chand, N.; Bajpai, S.K. Copper alginate–cotton cellulose (CACC) fibers with excellent antibacterial properties. J. Eng. Fiber. Fabr. 2009, 4, 24–35. [Google Scholar] [CrossRef]
- Bajpai, S.K.; Bajpai, M.; Sharma, L. Copper nanoparticles loaded alginate–impregnated cotton fabric with antibacterial properties. J. Appl. Polym. Sci. 2012, 126, 319–326. [Google Scholar] [CrossRef]
- Heliopoulos, N.S.; Kouzilos, G.N.; Giarmenitis, A.I.; Papageorgiou, S.K.; Stamatakis, K.; Katsaros, F.K. Viscose fabric functionalized with copper and copper alginate treatment toward antibacterial and UV blocking properties. Fibers Polym. 2020, 21, 1238–1250. [Google Scholar] [CrossRef]
- Heliopoulos, N.S.; Papageorgiou, S.K.; Galeou, A.; Favvas, E.P.; Katsaros, F.K.; Stamatakis, K. Effect of copper and copper alginate treatment on wool fabric. Study of textile and antibacterial properties. Surf. Coat. Technol. 2013, 235, 24. [Google Scholar] [CrossRef]
- Scopus Base. 12814 Documents Results on Alginates. Available online: https://www-1scopus-1com-10000145w03fc.han.p.lodz.pl/results/results.uri?numberOfFields=0&src=s&clickedLink=&edit=&editSaveSearch=&origin=searchbasic&authorTab=&affiliationTab=&advancedTab=&scint=1&menu=search&tablin=&searchterm1=alginates&field1=TITLE_ABS_KEY&dateType=Publication_Date_Type&yearFrom=Before+1960&yearTo=Present&loadDate=7&documenttype=All&accessTypes=All&resetFormLink=&st1=alginates&st2=&sot=b&sdt=b&sl=24&s=TITLE–ABS–KEY%28alginates%29&sid=31a31ef4754f2b4287c807b35585f4eb&searchId=31a31ef4754f2b4287c807b35585f4eb&txGid=db81be6eb51e1f2dee457d6275b329e1&sort=plf–f&originationType=b&rr= (accessed on 12 December 2020).
- Scopus Base. 3534 Documents Results on Alginate Composites. Available online: https://www-1scopus-1com-10000145w03fd.han.p.lodz.pl/results/results.uri?numberOfFields=0&src=s&clickedLink=&edit=&editSaveSearch=&origin=searchbasic&authorTab=&affiliationTab=&advancedTab=&scint=1&menu=search&tablin=&searchterm1=alginate++composites+&field1=TITLE_ABS_KEY&dateType=Publication_Date_Type&yearFrom=Before+1960&yearTo=Present&loadDate=7&documenttype=All&accessTypes=All&resetFormLink=&st1=alginate++composites+&st2=&sot=b&sdt=b&sl=36&s=TITLE–ABS–KEY%28alginate++composites+%29&sid=49cbf4a20bebe6548c33dbebccd109e8&searchId=49cbf4a20bebe6548c33dbebccd109e8&txGid=b35ba7e690e08ac59a51dd1904037cab&sort=plf–f&originationType=b&rr== (accessed on 12 December 2020).
- Scopus Base. 1282 Documents Results on Alginate Hybrids. Available online: https://www-1scopus-1com-10000145w03fd.han.p.lodz.pl/results/results.uri?numberOfFields=0&src=s&clickedLink=&edit=&editSaveSearch=&origin=searchbasic&authorTab=&affiliationTab=&advancedTab=&scint=1&menu=search&tablin=&searchterm1=alginate+hybrids++&field1=TITLE_ABS_KEY&dateType=Publication_Date_Type&yearFrom=Before+1960&yearTo=Present&loadDate=7&documenttype=All&accessTypes=All&resetFormLink=&st1=alginate+hybrids++&st2=&sot=b&sdt=b&sl=33&s=TITLE–ABS–KEY%28alginate+hybrids++%29&sid=49cbf4a20bebe6548c33dbebccd109e8&searchId=49cbf4a20bebe6548c33dbebccd109e8&txGid=b35ba7e690e08ac59a51dd1904037cab&sort=plf–f&originationType=b&rr== (accessed on 12 December 2020).
- Xua, W.; Shenc, R.; Yana, Y.; Gao, J. Preparation and characterization of electrospun alginate/PLA nanofibers as tissue engineering material by emulsion eletrospinning. J. Mech. Behav. Biomed. Mater. 2017, 65, 428–438. [Google Scholar] [CrossRef] [PubMed]
- Yang, M.; Yang, T.; Jia, J.; Lu, T.; Wang, H.; Yan, X.; Wang, L.; Yu, L.; Zhao, Y. Fabrication and characterization of DDAB/PLA alginate composite microcapsules as single–shot vaccine. RSC Adv. 2018, 8, 13612–13624. [Google Scholar] [CrossRef]
- Pandey, G.; Chaudhari, R.; Joshi, B.; Choudhary, S.; Kaur, J.; Joshi, A. Fluorescent biocompatible platinum–porphyrin–doped polymeric hybrid particles for oxygen and glucose biosensing. Sci. Rep. 2019, 9, 5029. [Google Scholar] [CrossRef]
- Kudzin, Z.H.; Kudzin, M.H.; Drabowicz, J.; Stevens, C.V. Aminophosphonic acids–phosphorus analogues of natural amino acids. Part 1: Syntheses of α–aminophosphonic acids. Curr. Org. Chem. 2011, 15, 2015–2071. [Google Scholar] [CrossRef]
- Drabowicz, J.; Jordan, F.; Kudzin, M.H.; Kudzin, Z.H.; Stevens, C.V.; Urbaniak, P. Reactivity of aminophosphonic acids. Oxidative dephosphonylation of 1–aminoalkylphosphonic acids by aqueous halogens. Dalton Trans. 2016, 45, 2308–2317. [Google Scholar] [CrossRef]
- Kudzin, Z.H.; Depczyński, R.; Kudzin, M.H.; Łuczak, J.; Drabowicz, J. 1–(N–Trifluoroacetylamino)alkylphosphonic acids: Synthesis and properties. Amino Acids 2007, 33, 663–667. [Google Scholar] [CrossRef]
- Kudzin, M.H.; Mrozińska, Z.; Walawska, A.; Sójka–Ledakowicz, J. Biofunctionalization of textile materials. 1. Biofunctionalization of poly(propylene) (PP) nonwovens fabrics by Alafosfalin. Coatings 2019, 9, 412. [Google Scholar] [CrossRef]
- Kudzin, M.H.; Mrozińska, Z. Biofunctionalization of textile materials. 2. Antimicrobial modification of poly(lactide) (PLA) nonwoven fabrics by fosfomycin. Polymers 2020, 12, 768. [Google Scholar] [CrossRef]
- Kudzin, M.H.; Mrozińska, Z. Biofunctionalization of textile materials.3. Biofunctionalization of poly (lactide) (PLA) nonwovens fabrics by KI. Coatings 2020, 10, 593. [Google Scholar] [CrossRef]
- Sójka–Ledakowicz, J.; Kudzin, M.H. Effect of plasma modification on the chemical structure of a polyethylene terephthalate fabrics surface. Fibres Text. East. Eur. 2014, 22, 118–122. [Google Scholar]
- Kudzin, M.H.; Mrozinska, Z.; Kaczmarek, A.; Lisiak–Kucinska, A. Deposition of copper on poly (lactide) non–woven fabrics by magnetron sputtering–fabrication of new multi–functional, antimicrobial composite. Materials 2020, 13, 3971. [Google Scholar] [CrossRef] [PubMed]
- Kudzin, M.H.; Kaczmarek, A.; Mrozińska, Z.; Olczyk, J. Deposition of copper on polyester knitwear fibers by a magnetron sputtering system. Physical properties, and evaluation of antimicrobial response of new multi–functional composite materials. Appl. Sci. 2020, 10, 6990. [Google Scholar] [CrossRef]
- Guo, X.; Wang, Y.; Qin, Y.; Shen, P.; Peng, Q. Structures, properties and application of alginic acid: A review. Int. J. Biol. Macromol. 2020, 162, 618–628. [Google Scholar] [CrossRef] [PubMed]
- Lu, L.; Liu, X.; Qian, L.; Tong, Z. Sol–gel transition in aqueous alginate solutions induced by cupric cations observed with viscoelasticity. Polym. J. 2003, 35, 804–809. [Google Scholar] [CrossRef]
- Hernandez, R.; Sacristan, J.; Mijangos, C. Sol/Gel Transition of aqueous alginate solutions induced by Fe2+ cations. Macromol. Chem. Phys. 2010, 211, 1254–1260. [Google Scholar] [CrossRef]
- Brus, B.; Urbanova, M.; Czernek, J.; Pavelkova, M.; Kubova, K.; Vyslouzil, J.; Abbrent, S.; Konefal, R.; Horsky, J.; Vetchy, D.; et al. Structure and dynamics of alginate gels cross–linked by polyvalent ions probed via solid state NMR spectroscopy. Biomacromolecules 2017, 18, 2478–2488. [Google Scholar] [CrossRef]
- Zhou, Q.; Kang, H.; Bielec, M.; Wua, X.; Cheng, Q.; Wei, W.; Dai, H. Influence of different divalent ions cross–linking sodium alginate–polyacrylamide hydrogels on antibacterial properties and wound healing. Carbohyd. Polym. 2018, 197, 292–304. [Google Scholar] [CrossRef]
- Yang, N.; Wang, R.; Rao, P.; Yan, L.; Zhang, W.; Wang, J.; Chai, F. The fabrication of calcium alginate beads as a green sorbent for selective recovery of Cu(II) from metal mixtures. Crystals 2019, 9, 255. [Google Scholar] [CrossRef]
- Wang, Z.Y.; Zhang, Q.Z.; Konno, M.; Saito, S. Sol–gel transition of alginate solution by the addition of various divalent cations: 13C–NMR spectroscopic study. Biopolymers 1993, 703–711. [Google Scholar] [CrossRef]
- Tiwari, A.; Tiwari, R.; Bajpai, A.K. Dynamic and equilibrium studies on adsorption of Cu(II) ions onto biopolymeric cross–linked pectin and alginate beads. J. Dispers. Sci. Technol. 2009, 30, 1208–1215. [Google Scholar] [CrossRef]
- Brinza, L.; Geraki, K.; Cojocaru, C.; Holdt, S.L.; Neamtu, M. Baltic Fucus vesiculosus as potential bio–sorbent for Zn removal: Mechanism insight. Chemosphere 2019, 238, 124652. [Google Scholar] [CrossRef] [PubMed]
- Pan, L.; Wang, Z.; Zhao, X.; He, H. Efficient removal of lead and copper ions from water by enhanced strength–toughness alginate composite fibers. Int. J. Biol. Macromol. 2019, 134, 223–229. [Google Scholar] [CrossRef] [PubMed]
- Li, S.S.; Song, Y.L.; Yang, H.R.; An, Q.D.; Xiao, Z.Y.; Zhai, S.R. Modifying alginate beads using polycarboxyl component for enhanced metal ions removal. Int. J. Biol. Macromol. 2020, 158, 493–501. [Google Scholar] [CrossRef]
- Lucaci, A.R.; Bulgariu, D.; Popescu, M.C.; Bulgariu, L. Adsorption of Cu(II) ions on adsorbent materials obtained from marine red algae Callithamnion corymbosum sp. oa. Water 2020, 12, 372. [Google Scholar] [CrossRef]
- The Perkin–Elmer Corporation. Analytical Methods for Atomic Absorption Spectroscopy; The Perkin–Elmer Corporation: Waltham, MA, USA, 1996; p. 46. [Google Scholar]
- Kister, G.; Cassanas, G.; Vert, M. Effects of morphology, conformation and configuration on the IR and Raman spectra of various poly (lactic acid)s. Polymer 1998, 39, 267–273. [Google Scholar] [CrossRef]
- Lawrie, G.; Keen, I.; Drew, B.; Chandler–Temple, A.; Rintoul, L.; Fredericks, P.; Grøndahl, L. Interactions between alginate and chitosan biopolymers characterized using FTIR and XPS. Biomacromolecules 2007, 8, 2533–2541. [Google Scholar] [CrossRef]
- Leal, D.; Matsuhiro, B.; Rossi, M.; Caruso, F. FT–IR spectra of alginic acid block fractions in three species of brown seaweeds. Carbohyd. Res. 2008, 343, 308–316. [Google Scholar] [CrossRef]
- Lim, S.F.; Zheng, Y.M.; Zou, S.W.; Chen, J.P. Characterization of copper adsorption onto an alginate encapsulated magnetic sorbent by a combined FT–IR, XPS, and mathematical modeling study. Environ. Sci. Technol. 2008, 42, 2551–2556. [Google Scholar] [CrossRef]
- Cardenas–Jiron, G.; Leal, D.; Matsuhiro, B.; Osorio–Roman, I.O. Vibrational spectroscopy and density functional theory calculations of poly– D–mannuronate and heteropolymeric fractions from sodium alginate. J. Raman Spectrosc. 2011, 42, 870–878. [Google Scholar] [CrossRef]
- Díaz–Visurraga, J.; Daza, C.; Pozo, C.; Becerra, A.; von Plessing, C.; García, A. Study on antibacterial alginate–stabilized copper nanoparticles by FT–IR and 2D–IR correlation spectroscopy. Int. J. Nanomed. 2012, 7, 3597–3612. [Google Scholar] [CrossRef] [PubMed]
- Nastaj, J.; Przewłocka, A.; Rajkowska–Myśliwiec, M. Biosorption of Ni(II), Pb(II) and Zn(II) on calcium alginate beads: Equilibrium, kinetic and mechanism studies. Pol. J. Chem. Technol. 2016, 18, 81–87. [Google Scholar] [CrossRef]
- Fertah, M.; Belfkira, A.; Dahmane, E.M.; Taourirte, M.; Brouillette, F. Extraction and characterization of sodium alginate from Moroccan Laminaria digitata brown seaweed. Arab. J. Chem. 2017, 10, 3707–3714. [Google Scholar] [CrossRef]
- Falk, M.; Ford, T.A. Infrared spectrum and structure of liquid water. Can. J. Chem. 1966, 44, 1699–1707. [Google Scholar] [CrossRef]
- International Organization for Standardization. Textiles. Solar UV Protective Properties. Method of Test for Apparel Fabrics; EN 13758-1:2002; International Organization for Standardization: Geneva, Switzerland, 2002. [Google Scholar]
- International Organization for Standardization. Determination of Antibacterial Activity—Agar Diffusion Plate Test; EN ISO 20645:2006. Textile Fabrics; International Organization for Standardization: Geneva, Switzerland, 2006. [Google Scholar]
- International Organization for Standardization. Testing of Textiles. Evaluation of the Action of Microfungi. Visual Method; PN EN 14119: 2005 point 10.5 (B2); International Organization for Standardization: Geneva, Switzerland, 2005. [Google Scholar]

| PLA | |||||||
|---|---|---|---|---|---|---|---|
| Atom | C | O | |||||
| At. % | 51.70 | 48.33 | |||||
| Std. dev. | 0.11 | 0.11 | |||||
| PLA–ALG–Na+ | |||||||
| Atom | C | O | Na | Ca | |||
| At. % | 71.41 | 28.42 | 0.10 | 0.08 | |||
| Std. dev. | 9.74 | 9.89 | 0.14 | 0.17 | |||
| PLA–ALG–Cu2+-1 | |||||||
| Atom | C | O | Cu | Na | S | Cl | Ca |
| At. % | 55.26 | 40.95 | 0.92 | 0.78 | 0.02 | 1.93 | 0.15 |
| Std. dev. | 1.26 | 2.59 | 1.26 | 1.10 | 0.04 | 0.65 | 0.21 |
| PLA–ALG–Cu2+-2 | |||||||
| Atom | C | O | Cu | Na | S | Cl | Ca |
| At. % | 35.16 | 19.96 | 15.06 | 5.87 | 1.18 | 21.44 | 1.30 |
| Std. dev. | 8.66 | 2.67 | 1.53 | 0.89 | 0.59 | 5.23 | 0.75 |
| Sample Name | Cu Concentration (g/kg) |
|---|---|
| PLA | 0.004 |
| PLA–ALG–Na+ | 0.003 |
| PLA–ALG–Cu2+-1 | 13.56 |
| PLA–ALG–Cu2+-2 | 73.91 |
| PLA | ALG–Na+ | ALG–Cu2+ | PLA–ALG–Cu2+ | |||||||
|---|---|---|---|---|---|---|---|---|---|---|
| (ν/cm−1) | Int./a | Assign. [84] | (ν/cm−1) | Int./a | Lit. bands (ν/cm−1) [85,86,87,88,89,90,91] | Assign. /[Ref.][88] | (ν/cm−1) | Int./a | (ν/cm−1) | Int./a |
| 3350 ± 350 | νs O–H | 3750 | 0.013/c | |||||||
| 3345 | 0.09/c | |||||||||
| 3200 | 0.14/b | νs O–H | 3200 | 0.01 | ||||||
| 3164 | 0.05 | |||||||||
| 2997 | 0.01 | νas CH3 | ||||||||
| 2947 | 0.01 | νs CH3 | ||||||||
| 2926 ± 1 | νs C–H | 2890 | 0.01 | |||||||
| 2897 | 0.01 | 2886 | 0.02 | 2886 | 0.01 | |||||
| 2389 | 0.02 | |||||||||
| 2341 | 0.01 | |||||||||
| 2322 | 0.01 | 2300 | 0.02 | 2337 | 0.01 | |||||
| 2265 | 0.01 | |||||||||
| 2270 | 0.01 | |||||||||
| 2216 | 0.01 | 2205 | 0.005 | |||||||
| 2134 | 0.01 | 2152 | 0.01 | |||||||
| 2111 | 0.01 | |||||||||
| 2021 | 0.01 | 2025 | 0.01 | |||||||
| 1957 | 0.01 | 1946 | 0.01 | |||||||
| 1833 | 0.02 | |||||||||
| 1760 | 0.07 | ν C=O | 1755 | 0.01 | ||||||
| 1650 [86] | νas COO– | 1690 | 0.02 | |||||||
| 1614 [85,86] | νas COO– | |||||||||
| 1588 | 0.03 | 1581 | 0.09 | 1588 | 0.02 | |||||
| 1452 | 0.02 | δas CH3 | ||||||||
| 1417 [85,86] | δ C–H; νs COO– | 1411 | 0.02 | |||||||
| 1400 | 0.02 | |||||||||
| 1388-1368 | 0.02 | δsCH3 | ||||||||
| 1368-1360 | 0.02 | δ1 CH+δsCH3 | ||||||||
| 1270 | 0.02 | δCH+νCOC | ||||||||
| 1301 (ms) | δ C–H | |||||||||
| 1295 | 0.02 | |||||||||
| 1130 | 0.07 | rasCH3 | 1124 (s) [86] | ν C–O, ν C–C, δ C–C–C, νas C–O–C/d | 1178 | 0.02 | ||||
| 1100-1090 | 0.11 | νs COC | 1096 (s) [86] | ν C–O, ν C–C, δ C–C–O; | 1073 | 0.03 | ||||
| 1045 | 0.08 | ν C–CH3 | 1034 (vs) [86] | νas C–O–C/d, ν C–O/d ν C–C | ||||||
| 1017 | 0.04 | 1013 | 0.03 | 1020 | 0.03 | |||||
| 875–860 | 0.03 | νC–COO | 866 | 0.02 | ||||||
| 826 (ms) [86] | δ C–O–C/d,δ C–C–C, δ C–C–O/d δ C–C–H, δω O–H | 810 | 0.03 | 810 | 0.02 | |||||
| 760–740 | 0.03 | δC=O | 776 (w) | rb, δ C–C–H, δ C–C–O | ||||||
| 715–695 | 0.03 | γC=O | 703(ms) | rb | ||||||
| 555 | 0.04 | δω O–H | 555 | 0.03 | ||||||
| Sample Name | Specific Surface Area SBET (m2/g) | Total Pore Volume V (cm3/g) | Average Pore Diameter D (nm) |
|---|---|---|---|
| PLA | 0.2405 ± 0.0220 | 9.084⋅10−4 | 13.85 |
| PLA–ALG–Na+ | 0.5548 ± 0.0452 | 1.581⋅10−3 | 10.54 |
| PLA–ALG–Cu2+-1 | 0.8429 ± 0.0109 | 3.450⋅10−3 | 16.59 |
| PLA–ALG–Cu2+-2 | 1.4280 ± 0.0220 | 4.661⋅10−3 | 13.26 |
| PLA | PLA–ALG–Na+ | PLA–LG–Cu2+-1 | PLA–ALG–Cu2+-2 | |
|---|---|---|---|---|
| UPF | 7.23 | 12.35 | 13.97 | 43.28 |
| average %T, λ = 290–400 nm | 16.46 | 10.63 | 9.03 | 4.43 |
| Sample Name | Bacterial Average Inhibition Zone (mm) | |
|---|---|---|
| Escherichia coli | Staphylococcus aureus | |
| PLA | 0 | 0 |
| PLA–ALG–Na+ | 0 | 0 |
| PLA–ALG–Cu2+−1 | 3 | 2 |
| PLA–ALG–Cu2+−2 | 3 | 4 |
| Sample Name | Fungal Average Inhibition Zone (mm) | ||
|---|---|---|---|
| Aspergillus niger | Chaetomium globosum | Visual Evaluation (Magnification 50×) | |
| PLA | 0 | 0 | Visible growth on sample surface |
| PLA–ALG–Na+ | 0 | 0 | |
| PLA–ALG–Cu2+−1 | 3 | 3 | No visible growth on sample surface |
| PLA–ALG–Cu2+−2 | 3 | 3 | |
| Parameter | |
|---|---|
| Polymer yields | 5 g/min |
| Mass per unit area of nonwovens | 160 g/m2 |
| Air flow rate | 7–8 m3/h |
| Temperature of the extruder: zone 1 | 195 °C |
| Temperature of the extruder: zone 2 | 245 °C |
| Temperature of the extruder: zone 3 | 260 °C |
| Head temperature | 260 °C |
| Air heater temperature | 260 °C |
| Assignments for Composites and Their Components | Coating Components (%) | ||
|---|---|---|---|
| Sodium Alginate Solution (ALG–Na+) | Copper(II) Chloride Solutions (CuCl2) | ||
| 0, 5% | 5% | 10% | |
| PLA | – | – | – |
| PLA–ALG–Na+ | + | – | – |
| PLA–ALG–Cu2+-1 | + | + | – |
| PLA–ALG–Cu2+-2 | + | – | + |
Publisher’s Note: MDPI stays neutral with regard to jurisdictional claims in published maps and institutional affiliations. |
© 2020 by the authors. Licensee MDPI, Basel, Switzerland. This article is an open access article distributed under the terms and conditions of the Creative Commons Attribution (CC BY) license (http://creativecommons.org/licenses/by/4.0/).
Share and Cite
Kudzin, M.H.; Boguń, M.; Mrozińska, Z.; Kaczmarek, A. Physical Properties, Chemical Analysis, and Evaluation of Antimicrobial Response of New Polylactide/Alginate/Copper Composite Materials. Mar. Drugs 2020, 18, 660. https://doi.org/10.3390/md18120660
Kudzin MH, Boguń M, Mrozińska Z, Kaczmarek A. Physical Properties, Chemical Analysis, and Evaluation of Antimicrobial Response of New Polylactide/Alginate/Copper Composite Materials. Marine Drugs. 2020; 18(12):660. https://doi.org/10.3390/md18120660
Chicago/Turabian StyleKudzin, Marcin H., Maciej Boguń, Zdzisława Mrozińska, and Anna Kaczmarek. 2020. "Physical Properties, Chemical Analysis, and Evaluation of Antimicrobial Response of New Polylactide/Alginate/Copper Composite Materials" Marine Drugs 18, no. 12: 660. https://doi.org/10.3390/md18120660
APA StyleKudzin, M. H., Boguń, M., Mrozińska, Z., & Kaczmarek, A. (2020). Physical Properties, Chemical Analysis, and Evaluation of Antimicrobial Response of New Polylactide/Alginate/Copper Composite Materials. Marine Drugs, 18(12), 660. https://doi.org/10.3390/md18120660

